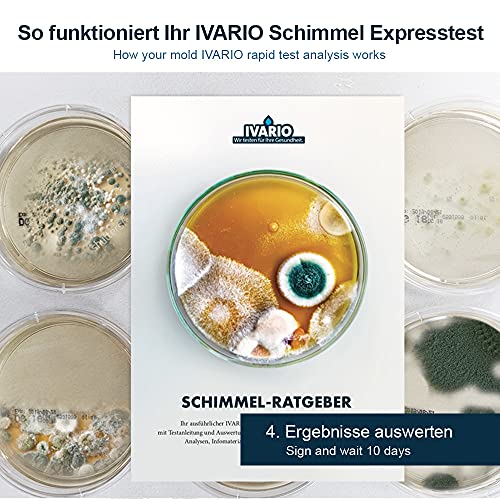

Schimmeltest – Exprestest voor thuis: de schimmeltest – incl. gemakkelijk te begrijpen handleiding (mogelijk niet…
De IVARIO-schimmeltest om zelf te evalueren voor een snel overzicht van je schimmelvoorkomen. Eenvoudig te gebruiken zonder voorkennissen, bijvoorbeeld in de slaapkamer, woonkamer, kelder, kantoor, caravan, enz.
Luchtschimmeltest voor het controleren van een ruimte + schimmelrator. Testset voor zelfstandig testen en evalueren. Test nu je lucht in de kamer op schimmel en krijg snel zekerheid.
Inclusief gedetailleerde handleiding voor de proefperiode en alles wat je over schimmel moet weten, in onze schimmeladviseur. Ondersteunt bij het oplossen van gezondheidsproblemen, zoals astma of andere aandoeningen van de luchtwegen
Amazon.nl Price: €24.20 (as of 09/04/2023 18:38 PST- Details) & FREE Shipping.
De lucht in de ruimte op schimmel laten testen – snel en eenvoudig met onze snelle schimmeltest
Bij de bestelling van onze snelle schimmeltest ontvang je een testset – incl. gedetailleerde handleiding (mogelijk niet beschikbaar in het Nederlands) – voor zelfcontrole van je kamers op schimmel.
Zo eenvoudig is het:
- Verzending binnen 24 uur na succesvolle bestelling (maandag – vrijdag)
- De schimmeltest-set bevat naast een voedingsbodem ook een schimmelgids met een gedetailleerde handleiding (mogelijk niet beschikbaar in het Nederlands), een evaluatietabel en veel wetenswaardigheden over schimmelbesmetting.
- Evalueer de koloniegroei van je voedingsbodem al na 10 dagen, de eerste resultaten krijg je meestal al na 36 uur.
Omtrek van de schimmel-sneltest.
Onze snelle schimmeltest maakt het mogelijk om een ruimte te controleren en de zelfevaluatie van het schimmelpreventie aan de hand van de schimmel-raadgever.
Resultaat beoordeling.
Na 10 dagen kun je je resultaat zelf evalueren aan de hand van de evaluatietabel in de schimmel-adviesgever. Voor het beoordelen van je testresultaat staat ons team van experts per e-mail en telefonisch gratis voor vragen ter beschikking.
Let op:
Het gaat bij deze test om geen laboratoriumanalyse. De evaluatie van uw testresultaat vindt door uzelf met behulp van de schimmel-raadgever.
De IVARIO-schimmeltest om zelf te evalueren voor een snel overzicht van je schimmelvoorkomen. Eenvoudig te gebruiken zonder voorkennissen, bijvoorbeeld in de slaapkamer, woonkamer, kelder, kantoor, caravan, enz.
Luchtschimmeltest voor het controleren van een ruimte + schimmelrator. Testset voor zelfstandig testen en evalueren. Test nu je lucht in de kamer op schimmel en krijg snel zekerheid.
Inclusief gedetailleerde handleiding voor de proefperiode en alles wat je over schimmel moet weten, in onze schimmeladviseur. Ondersteunt bij het oplossen van gezondheidsproblemen, zoals astma of andere aandoeningen van de luchtwegen
Jouw voordelen: verzending binnen 24 uur na bestelling (in weekdagen) – geen voorkennis nodig – incl. handleiding (mogelijk niet beschikbaar in het Nederlands) – eerste resultaten meestal Al na 36 uur – Gratis telefonisch deskundig advies
Een van de toonaangevende online aanbieders van milieuanalyses sinds 2015 – Nieuw bij Amazon verkrijgbaar. IVARIO maakt deel uit van de GBA Group – een van de toonaangevende laboratoriumdiensten in Europa. De laboratoria van de GBA Group staan sinds 1989 voor de hoogste normen voor laboratoriumuitrusting, analysemethoden en onderzoeksresultaten.
Specification: Schimmeltest – Exprestest voor thuis: de schimmeltest – incl. gemakkelijk te begrijpen handleiding (mogelijk niet…
|